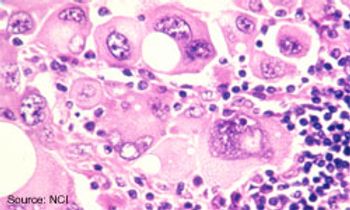

The FDA has expanded the approval for enzalutamide (Xtandi) to include the treatment of men with chemotherapy-naive metastatic castration-resistant prostate cancer (mCRPC).

The FDA has expanded the approval for enzalutamide (Xtandi) to include the treatment of men with chemotherapy-naive metastatic castration-resistant prostate cancer (mCRPC).

The combination of multiple independent factors minimized the impact of baseline stage for predicting locoregional recurrence (LRR) following neoadjuvant chemotherapy in patients with breast cancer.

Cabozantinib (Cometriq) failed to significantly extend overall survival (OS) compared with prednisone as a treatment for men with metastatic castration-resistant prostate cancer (mCRPC).

The FDA has approved eltrombopag (Promacta) as a treatment for patients with severe aplastic anemia (SAA) following an insufficient response to immunosuppressive therapy, based on data from an open-label, single-arm phase II trial.

A New Drug Application has been submitted to the FDA for palbociclib plus letrozole as a frontline treatment for postmenopausal women with ER-positive, HER2-negative advanced breast cancer.

The FDA has approved bevacizumab in combination with paclitaxel and cisplatin or paclitaxel and topotecan as a treatment for patients with persistent, recurrent, or metastatic cervical cancer, based on the improvement in OS in the phase III GOG 240 study.

Treatment with single-agent carfilzomib (Kyprolis) was unable to significantly extend overall survival (OS) compared with best supportive care in heavily pretreated patients with multiple myeloma.

Significantly extended overall survival (OS) and progression-free survival (PFS) was seen with oral nucleoside TAS-102 treatment in patients with metastatic colorectal cancer (mCRC) refractory to standard therapies.

The FDA has approved Cologuard as the first noninvasive stool-based DNA test for the detection of CRC in asymptomatic individuals at average risk, based on clinical trial results demonstrating superiority to the fecal immunochemical test.

The FDA has expanded the bortezomib (Velcade) label to allow for retreatment in patients with multiple myeloma who previously responded to the proteasome inhibitor.

Women harboring a loss-of-function mutation in the PALB2 gene demonstrated an increased risk of developing breast cancer that was similar to the predisposition seen with mutations in BRCA.

The FDA has assigned a priority review designation to the JAK1/2 inhibitor ruxolitinib as treatment for patients with polycythemia vera who are resistant or intolerant to hydroxyurea.

The combination of carfilzomib, carfilzomib, and low-dose dexamethasone extended PFS by 8.7 months compared with lenalidomide and dexamethasone alone for patients with relapsed multiple myeloma.

The FDA has expanded the approval of ibrutinib (Imbruvica) to include the treatment of patients with chronic lymphocytic leukemia (CLL) who have received at least one previous therapy and harbor a 17p deletion.

Extended adjuvant treatment with neratinib (PB272, HKI-272) significantly improved disease-free survival (DFS) compared with placebo for patients with HER2-positive breast cancer who received prior adjuvant trastuzumab.


The FDA has assigned a priority review designation to bevacizumab (Avastin) in combination with chemotherapy for patients with recurrent platinum-resistant ovarian cancer.

The somatostatin analog lanreotide (Somatuline Depot) significantly prolonged progression-free survival (PFS) compared with placebo for patients with metastatic gastroenteropancreatic NETs.

The FDA has assigned a priority review designation to bevacizumab (Avastin) plus chemotherapy as a treatment for patients with persistent, recurrent, or metastatic cervical cancer.

A phase III study comparing trametinib (Mekinist) plus dabrafenib (Tafinlar) with single-agent vemurafenib (Zelboraf) has been stopped early following a positive interim analysis.

The combination of the BRAF inhibitor vemurafenib and the MEK inhibitor cobimetinib significantly improved progression-free survival (PFS) compared with vemurafenib alone for patients with untreated BRAFV600-mutated advanced melanoma.

The investigational CD19-targeted chimeric antigen receptor (CAR) therapy CTL019 has received a breakthrough therapy designation from the FDA as a potential treatment for pediatric and adult patients with relapsed/refractory acute lymphoblastic leukemia (ALL).

The PD-1 inhibitor nivolumab and the second-generation ALK inhibitor alectinib have each gained their first approvals as treatments for patients in Japan.

Second-line treatment with MM-398 plus 5-FU and leucovorin extended OS, PFS, and ORR compared with 5-FU and leucovorin alone for patients with metastatic pancreatic cancer.

The FDA’s ODAC voted 11-2 against the accelerated approval of the PARP inhibitor olaparib as a maintenance therapy for women with platinum-sensitive relapsed ovarian cancer with germline BRCA mutations.
Frontline treatment with the anti-PD-1 agent nivolumab significantly extended overall survival (OS) when compared with dacarbazine for patients with metastatic or unresectable melanoma.

SAR650984 demonstrated encouraging efficacy as a monotherapy and in combination with dexamethasone and lenalidomide without reaching a maximum tolerated dose in patients with heavily pretreated multiple myeloma.

The novel agents idelalisib and ABT-199 in combination with rituximab have demonstrated impressive activity with manageable toxicity for patients with relapsed or refractory chronic lymphocytic leukemia (CLL).

The intratumoral injection talimogene laherparepvec (T-VEC) demonstrated promise in combinations and utility as a monotherapy in certain subsets of patients with unresectable melanoma.

Treatment with single-agent ibrutinib (Imbruvica) dramatically increased progression-free survival (PFS) by nearly 80% and significantly extended overall survival (OS) by 57% compared with ofatumumab in patients with relapsed or refractory chronic lymphocytic leukemia (CLL).